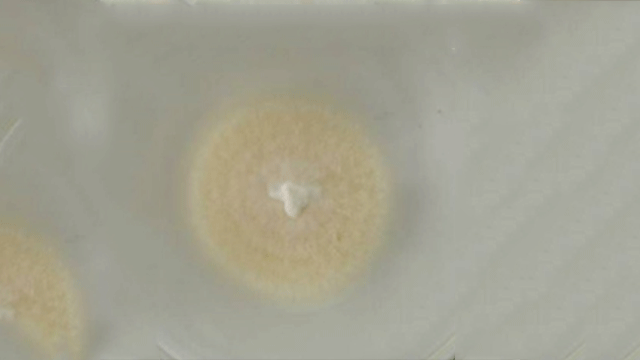
36033

联系邮箱:sale@zenongshengwu.com
服务热线:400-1579-116
公司地址:苏州工业园林泉街377号
网站制作:牛商股份(股票代码:830770)
 关注泽农生物
关注泽农生物
 泽农生物手机网
泽农生物手机网
备案号:苏ICP备18019782号 网站版权注册 仿冒必究! 百度统计
松墨天牛又名松褐天牛,是松材线虫病的主要传播媒介,同时又是松林的重要蛀干昆虫。松墨天牛会蛀食树干和大枝条的韧皮部和木质部,破坏组织,影响水分、养分运输,松材线虫又会趁机进入松树内部,引起松树枯死,严重降低松树出材率、材质,造成大量的经济损失。
松墨天牛有着众多的防治手段,但近几年来生物防治的热度在慢慢爬升。为保证森林生态系统良性循环,加强环境保护建设,国内外的植保研究人员都在积极探索着生物防治技术,寻找松墨天牛 有效的天敌并加以研究。因此,笔者本次将为大家介绍松墨天牛面前主流的应用天敌之一球孢白僵菌。

球孢白僵菌是害虫的寄生性天敌,接触害虫后,分泌多种昆虫表皮降解酶,穿透害虫体壁进入体腔,在虫体内迅速繁殖;同时分泌大量白僵菌,破坏害虫的机体组织,使害虫因不能维持正常的生命活动而死亡。球孢白僵菌防对寄主有较强的选择性和专化性,对高等动植物无害作用,不会对环境造成污染。因为害虫基本不会形成抗药性,因此具有持续功效。
球孢白僵菌不光对松墨天牛有效,也能杀手松树的另一种重要害虫松毛虫。使用一般以兑水喷洒形式,按产品规定比例兑水。球孢白僵菌使用的注意事项是要尽量选择阴天使用,在气温20-30度条件下,球孢白僵菌防治效果明显。球孢白僵菌使用应避免同时使用化学药剂,管氏肿腿蜂倒是可以同时使用。
苏州泽农生物科技有限公司研发团队致力农林学昆虫研究,掌握核心昆虫松墨天牛 资源。目前已与南京林业大学、苏州大学、浙江师范大学及新加坡国立大学科研合作,致力于打造绿色环保产业。